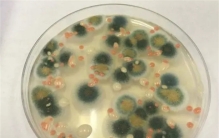

切尔诺贝利核电站的附近发现了一种真菌,这种真菌的奇特之处在于它能够在核辐射的影响下茁壮成长,这种强大的抵御能力引起了科学界的关注,天文学、材料学、生物学和物理学都在试图搞清楚该真菌的存在原理,并试图应 ...
2023-7-30 19:46

在历史的长河中,世界经受了许多重大的自然灾害,遭受严重损失。人类总是在错误中更正自己的行为,对于工程建筑同样如此。下面跟世界之最网小编一起来看看世界十大著名工程灾难,切尔诺贝利核泄漏位列第八,想了解更 ...
2022-6-8 20:37

1986年,位于乌克兰的切尔诺贝利核电站发生了核泄漏事故,30多年后,该灾难对人类和环境仍旧产生影响,这次事故也被认为是世界上最严重的核电站事故,数百万人受到核辐射侵害,一直到今天,影响也未曾终结,跟随小编 ...
2021-12-21 20:48

世界最大核电站,日本柏崎核电站是世界上发电能力最大的核电站 ...
说起日本的核电站,许多人就会想到福岛核泄漏事件,这可以说是许多人的噩梦了。因为福岛的核泄漏,世界最大核电站柏崎核电站都被关停了。柏崎核电站全称柏崎刈羽核电站,是日本最大核电站,也是世界上发电能力最大的 ...
2021-8-30 16:17

在1989年的时候,世界上发生了一次非常严重的核事故,因为核电站在调试时发生了爆炸,整个事故所造成的火灾导致了9天的大火,同时性放射性的气体也散发到空气中,严重影响了人们的健康,所以建造了切尔诺贝利石棺将 ...
2021-8-9 10:47

小的时候,从奶奶的口中得知猫咪是一种很神奇的动物,神奇所在之处就是它的眼睛,它可以看见人类看不见的阴物,天性本来就爱猫咪的我,从不停止于了解这世界上的各种猫咪,前段时间网上火了一张乌克兰巨猫的图片,令 ...
2021-4-18 18:54

核辐射给人们带来的危害,可想而知。近日,在伊朗首都街头,惊现巨大老鼠。这些老鼠,重达四五公斤,看着十分的诡异,用一般的捕鼠器材根本抓不了它们。于是,伊朗政府派出强有力的狙击队,成功捕杀了两千多只的伊朗 ...
2019-7-14 07:05

1986年发生在切尔诺贝利核电站的一次泄漏事件,造成多人死亡。当时,有一帮考察队员进入此核电站时,却突遭一群巨鼠的袭击。9人中,只有一个活着出来。而这些袭击人的老鼠,被称之为切尔诺贝利巨鼠。咱们一起来了解 ...
2019-7-14 03:56

随着科学技术不断的进步,我们也进入了电气时代,现在的生活离不开电,我们使用的很多产品都是电子产品,这些产品渐渐的成为我们生活的一部分,而想要使用这些电子产品就需要有电力的供应,这个时候发电就成为一个重 ...
2019-7-11 15:23

在我们身边每天都会发生一些事情,而这其中有些事情是非常的令人震惊的,历史上有许多大型事故发生,这些事故会造成人们巨大的损失,相信很多人都了解过核发电,这是一个非常有效的发电方式,但是如果对它处理不好, ...
2019-7-11 14:25

世界十大人为灾难,切尔诺贝利核泄漏辐射量相当于500颗原子弹 ...
虽然有些天灾是躲不过去的,但有一个词语可以很好的反应天灾和人祸之间的关系,那就是天灾人祸,虽然没有固定因果关系,但大部分的天灾都是因为人为祸害,纯粹的自然灾害,比较少见,那么历史上有哪些严重的人为灾难 ...
2019-7-11 13:42

切尔诺贝利曾经被认为是最安全、最可靠的核电站,但没想到后来却发生了切尔诺贝利核事故,这起被称为是史上最严重的核事故,带来了极为惨痛的灾难,甚至使得切尔诺贝利整座城市都沦为荒芜,就连1000多公里外的地区, ...
2019-7-11 06:21

2019-7-11 01:55